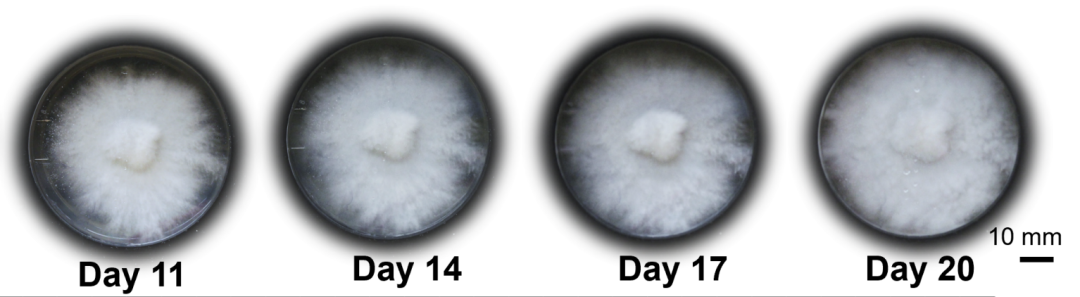
af93c1299094e1d06f7d8c0afab3a28c.png

克雷西 发自 凹非寺
量子位 | 公众号 QbitAI
What……控制机器人的工具,竟然可以是蘑菇?
有视频为证,这个长得像海星,在桌面上走来走去的机器人,里面就装上了一颗“蘑菇大脑”。
这是一项来自美国康奈尔大学和意大利佛罗伦萨大学的正经仿生学研究,已经登上了Science子刊。

他们建立了生物和机器人之间的一种“通信接口”,用蘑菇体内的电脉冲作为控制机器人的信号。
下面就来详细了解~
捕捉电信号,控制机器人
为了能用真菌产生的生物信号作为机器人的控制信号,研究人员开发了一种菌丝体电接口,可以进行长期稳定的生物电捕捉和记录。
用于捕捉信号的电极,和菌丝体培养皿一同被置于专门设计的3D打印支架上。

实验中,研究人员选用的真菌名叫刺芹侧耳(学名Pleurotus eryngii),当然它还有一个我们更熟悉的名字叫做——杏鲍菇。
作者将菌种接种于马铃薯葡萄糖琼脂(PDA)培养基上,放入支架固定的培养皿内,在25°C下培养。
培养皿分(直径)60mm和150mm两种尺寸,分别培养约3周和5周,直到菌丝体完全长满培养皿。
在培养过程中和培养完成后,作者对菌丝产生的电信号进行了持续记录。
记录之前,研究者将不锈钢针电极插入支架的电极固定槽,两个记录电极平行放置,间距10mm,距培养基表面10-11mm;参考电极与记录电极垂直,距表面1mm。
为了屏蔽外界电磁干扰,研究人员将装有菌丝体和电极的支架置于自制的法拉第笼内,以10S/s的采样率记录电信号,持续30余天。

对采集到的原始电信号数据,研究者用Python进行了分析处理——
首先,作者将幅值小于5μV的信号作为噪声剔除,然后进行了平滑去噪和三阶多项式拟合。
之后使用SciPy库中的相应函数检测电位尖峰并尖峰半高宽(即持续时间),最后对提取出的尖峰按幅值、宽度等参数进行统计分析,绘制直方图等图表。
分析发现,菌丝体在整个培养期内能够稳定产生自发的电位尖峰,平均幅值约135μV,最大幅值1868μV,平均频率约0.12次/秒。

为了研究光照对菌丝体电活动的影响,研究者使用汞灯系统,通过光纤和准直器将紫外光垂直照射在菌丝体上表面,光斑直径约1cm。

作者测试了不同光强度(0.1-1W/cm²)、照射距离(12-20cm)和照射时间(2-12秒)的组合。
结果表明,紫外光照可诱发幅值高达18000μV、持续时间约4秒的电位尖峰,蓝光也有类似效果但幅值较低,红光和白光则未观察到明显效果。

在了解了真菌产生电信号以及受光照影响的规律后,研究人员用其利产生的节律性正负电位尖峰信号,实现了机器人的控制。
具体来说,他们设计了一个柔性多足步行机器人(也就是开头看到的“海星”),将菌丝体产生的电信号经过阈值检测等处理,转化为数字控制信号,通过Arduino单片机输出PWM波控制气动阀和直流电机。

实验表明,菌丝体可以稳定控制机器人持续运动数十分钟。
当用紫外光刺激菌丝体时,机器人的运动状态也随之发生改变,实现了机器人的实时控制。

蘑菇并未产生意识,但“生物传感器”值得研究
对于这项研究的意义,康奈尔大学机械与航空航天工程教授Rob Shepherd表示:
通过将菌丝体培养到机器人的电子器件中,我们能够让生物混合机器感知环境并做出响应。
未来机器人的潜力可能是感知中耕作物的土壤化学成分,并决定何时添加更多肥料。
英国《独立报》更是将其描绘为蘑菇“学会了爬行”。

不过对这一说法,有网友在仔细读了论文后表示了质疑。
研究者只是构建了一套真菌的电活动与机器人运动之间的对应规则,而不是真菌(产生了意识)控制了机器人。

蘑菇“学会了爬行”这个说法也不准确,因为它们并没有真正意义上“学”到任何东西。

但如果像Rob Shepherd教授所说,能够建立起环境-生物-机器之间的控制链条,那么作为“传感器”的生物有没有意识,也就不是关键问题。
还有人脑洞大开,表示蘑菇在这里仿佛发挥的是一个随机数生成器的作用,甚至有人好奇是不是真的能当随机数生成器来用……

论文地址:
https://www.science.org/doi/10.1126/scirobotics.adk8019
参考链接:
[1]https://www.independent.co.uk/tech/robot-mushroom-biohybrid-robotics-cornell-b2606970.html
[2]https://news.ycombinator.com/item?id=41451668
— 完 —
量子位年度AI主题策划正在征集中!
欢迎投稿专题 一千零一个AI应用,365行AI落地方案
或与我们分享你在寻找的AI产品,或发现的AI新动向

点这里👇关注我,记得标星哦~
534

被折叠的 条评论
为什么被折叠?



